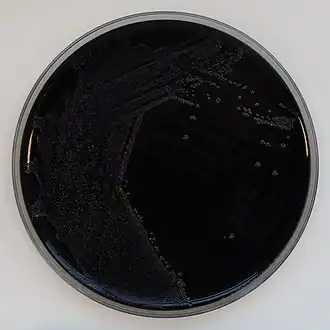
Espécime de Berlim

Bordetella parapertussis
Bordetella parapertussis
| |||||||||||||||
|---|---|---|---|---|---|---|---|---|---|---|---|---|---|---|---|
![]() Espécime de Berlim | |||||||||||||||
| Classificação científica | |||||||||||||||
| |||||||||||||||
| Nome binomial | |||||||||||||||
| Bordetella parapertussis (Eldering e Kendrick, 1938) Moreno-López, 1952 | |||||||||||||||
A Bordetella parapertussis é uma pequena bactéria gram-negativa do genus Bordetella que está adaptada para colonizar o trato respiratório dos mamíferos.[1] A pertússis, causada pela B. parapertussis, se manifesta com sintomas semelhantes à doença derivada da B. pertussis mas tende geralmente a ser menos severa .[2] A imunidade derivada da B. pertussis não protege contra infecção pela B. parapertussis, entretanto, porque o antígeno O só é encontrado na B. parapertussis. Este antígeno protege a B. parapertussis contra anticorpos específicos à B. pertussis, então a bactéria fica livre para colonizar os pulmões do hospedeiro sem estar sujeita ao ataque prévio de anticorpos. Estas descobertas sugerem que a B. parapertussis evoluiu numa população hospedeira que já tinha desenvolvido imunidade à B. pertussis, onde capaz de fugir da imunidade da B. pertussis encontrou uma vantagem.[3]
Duas linhagens de B. parapertussis tem sido descritas. A primeira afeta humanos e é responsável por uma minoria de casos da doença pertússis (também conhecida como coqueluche).[4] A segunda linhagem, ovina, causa pneumonia não-crônica progressiva em carneiros.[5] Ambas as linhagens são pensadas de terem evoluído de uma ancestral aparentada, a B. bronchiseptica.[6] Esta doença pode ser sintomática ou assintomática e pode predispor os hospedeiros à uma infecção secundária.[7]
Referências
- ↑ Ryan KJ; Ray CG (editors) (2004). Sherris Medical Microbiology 4th ed. [S.l.]: McGraw Hill. ISBN 0838585299
- ↑ Heininger U, Stehr K, Schmitt-Grohé S, Lorenz C, Rost R, Christenson P, Uberall M, Cherry J (1994). «Clinical characteristics of illness caused by Bordetella parapertussis compared with illness caused by Bordetella pertussis». Pediatr Infect Dis J. 13 (4): 306–9. PMID 8036048. doi:10.1097/00006454-199404000-00011
- ↑ Wolfe D, Goebel E, Bjornstad O, Restif O, Harvil E (2007). «The O Antigen Enables Bordetella parapertussis To Avoid Bordetella pertussis-Induced Immunity». Infection and Immunity. 75 (10): 4972–9. PMC 2044517
. PMID 17698566. doi:10.1128/IAI.00763-07
- ↑ Cherry J (1996). «Historical review of pertussis and the classical vaccine». J Infect Dis. 174 Suppl 3: S259–63. PMID 8896526
- ↑ Porter J, Connor K, Donachie W (1994). «Isolation and characterization of Bordetella parapertussis-like bacteria from ovine lungs». Microbiology. 140 ( Pt 2): 255–61. PMID 8180690
- ↑ van der Zee A, Mooi F, Van Embden J, Musser J (1997). «Molecular evolution and host adaptation of Bordetella spp.: phylogenetic analysis using multilocus enzyme electrophoresis and typing with three insertion sequences». J Bacteriol. 179 (21): 6609–17. PMC 179586
. PMID 9352907
- ↑ Porter J, Connor K, Krueger N, Hodgson J, Donachie W (1995). «Predisposition of specific pathogen-free lambs to Pasteurella haemolytica pneumonia by Bordetella parapertussis infection». J Comp Pathol. 112 (4): 381–9. PMID 7593760. doi:10.1016/S0021-9975(05)80019-2